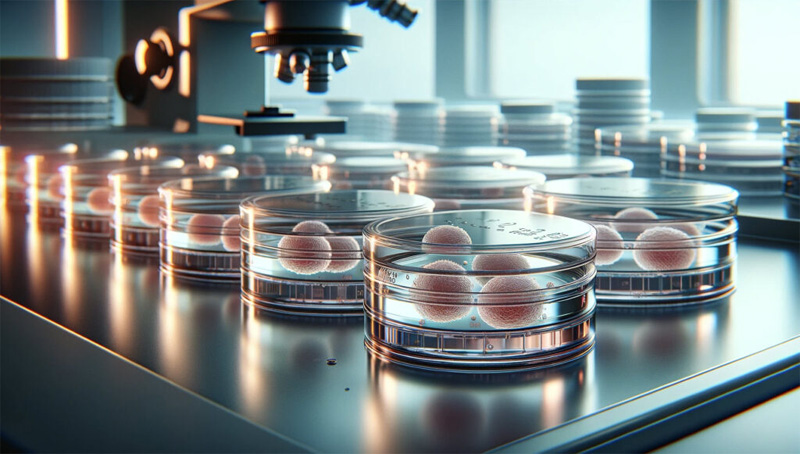
新闻图片1

微信扫一扫
关注公众号
产品分类
- 酶及底物 (521)
- 免疫学 (3046)
- 标准品/对照品 (131)
- 生物制药与疫苗 (384)
- 分离纯化 (37)
- 生化试剂 (28750)
- 分子生物学 (21)
- WAKO (13608)
- Jackson ImmunoResearch (2012)
- Ludger 糖链分析 (87)
- Lumiprobe活性染料 (3)
- abcam (39100)
- Merck-Sigma (44441)
- MP Bio (11006)
- 试剂 (9706)
- 健康原料 (24)
- 新型材料 (345)
- 仪器分析 (1025)
- 合作品牌 (45288)
- Aalto
- AAT Bioquest
- AbD
- Acros
- Active Motif
- Advanced Targeting Systems
- Ambion
- AnaSpec
- AssayDesign
- Avanti
- Bangs Laboratories
- BioPorto
- BioSource
- bioworld
- cayman
- Chemicon
- Clontech
- CST
- DiFco
- Epigentek
- hampton
- Himedia
- Hyclone
- ldmsapp
- Innova Biosciences
- Invent
- J.T.BAKER
- KALEN
- KPL
- lifespan
- MRC
- Phytotech
- Pierce
- Prozyme
- Qiagen
- R&D
- Roche
- Santa Cruz
- Serotec
- Vector
- Worthington
- 其他分类 (8)
服务保证
西宝风采
公司新闻
无血清培养基重要添加剂 - 胰岛素-转铁蛋白-硒(ITS)
发布时间:2024-11-29 13:02 | 点击次数:709
由于血清在细胞培养应用中的缺点使得近些年在科学研究和工业生产领域,人们对无血清培养基的需求日益增大。近年来无血清培养基在生物制品的生产,如疫苗、单克隆抗体和重组蛋白等,同时也在细胞生物学、药理学、肿瘤学研究中应用越来越广。
无血清培养基除了能够克服血清的缺点还具有两个突出的优点,即可针对特定的细胞类型配制专用的培养基,以及可精确地控制细胞的增殖和分化过程。
基础的无血清培养基虽然营养丰富、可足量提供细胞所必须的营养成分,但通常还需要进一步添加特定的组分,如生长因子、脂肪酸、维生素和微量元素等。多年的实践表明,对于大多数细胞的无血清及低血清培养基,在基础培养基(多为DMEM/F12)中必须额外添加ITS(胰岛素-转铁蛋白-硒)。
ITS补剂
ITS得名于其组成型营养成分,即胰岛素(insulin)、转铁蛋白(transferrin)和硒(selenium)。这种营养成分混合物的变体形式包括SITE(硒、胰岛素、转铁蛋白、乙酉享胺)和还添加了亚油酸、油酸和/或牛血清白蛋白(BSA)的增强型制剂。
胰岛素 (Insulin)
可促进细胞生长,调节细胞对葡萄糖、氨基酸和脂类的摄取和利用。胰岛素也具有抵抗细胞凋亡的作用。在哺乳动物细胞的无血清培养时,重组胰岛素的添加浓度远高于其生理浓度,这样胰岛素除能与胰岛素受体(Insulin Receptor, IR)结合,发挥代谢调节和抗凋亡作用外,还可通过激活胰岛素样生长因子(IGF-I)的受体,发挥促有丝分裂和抗凋亡作用,产生生长因子效应。
转铁蛋白 (Transferrin)
是血清中富含的一种糖蛋白,能与三价铁离子可逆性结合。其在铁离子的转运和代谢中发挥着至关重要的作用,同时也是一种重要的胞外抗氧化剂。因此,转铁蛋白是无血清培养基必不可少的添加物。转铁蛋白最初是从血清中分离出来的,然而由于批间差大和安全性差等问题,重组的转铁蛋白被越来越广泛地应用。从各种表达系统,包括植物中获得的重组转铁蛋白均具有相似的活性。
硒 (Selenium)
是一种微量元素,它是谷胱甘肽过氧化物酶、硫氧还蛋白还原酶和其他抗氧化物酶的关键组分。硒已被确认是无血清培养基的必须添加物。
乙酉享胺 (Ethanolamine)
是一种有机化合物,它既是伯胺也是伯醇,可作为磷脂合成的前体。乙酉享胺在杂交瘤细胞的增殖中发挥着重要的作用,因而经常添加到杂交瘤细胞的无血培养基中。乙酉享胺也用于其它类型细胞的无血清培养。
Seebio提供三种不同的ITS,即:常规通用的ITS-G、用于贴壁细胞培养的ITS-A,以及适用于需要氨基乙醇的细胞(如支气管上皮细胞)类型培养的ITS-X。本产品经过滤灭菌,即开即用,使用时将所需量直接加入到液体培养基即可。
产品信息
|
产品名称
|
ITS-G Supplement(×100)
|
ITS-A Supplement(×100)
|
ITS-X Supplement(×100)
|
|
产品编号
|
090-06741
|
097-06751
|
094-06761
|
|
组分 (mg/L)
|
|||
|
胰岛素
|
1,000
|
1,000
|
1,000
|
|
转铁蛋白(Apo)
|
550
|
550
|
550
|
|
Na2SeO3
|
0.67
|
0.67
|
0.67
|
|
丙酮酸钠
|
-
|
11,000
|
-
|
|
乙酉享胺
|
-
|
-
|
200
|
|
KCl
|
400
|
400
|
400
|
|
NaCl
|
6,800
|
6,800
|
6,800
|
|
NaHCO3
|
2,200
|
2,200
|
2,200
|
|
NaH2PO4
|
121.73
|
121.73
|
121.73
|
|
D–葡萄糖
|
1,000
|
1,000
|
1,000
|
|
内毒素含量
|
≤ 0.6 EU/mL
|
||
产品列表
|
产品编号
|
产品名称
|
产品规格
|
|
090-06741
|
ITS-G Supplement(×100)
|
10mL
|
|
097-06751
|
ITS-A Supplement(×100)
|
10mL
|
|
094-06761
|
ITS-X Supplement(×100)
|
10mL
|


















